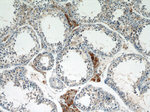
LC3 Antibody in Immunohistochemistry (Paraffin) (IHC (P))

Search
Proteintech
LC3 Polyclonal Antibody
{{$productOrderCtrl.translations['antibody.pdp.commerceCard.promotion.promotions']}}
{{$productOrderCtrl.translations['antibody.pdp.commerceCard.promotion.viewpromo']}}
{{$productOrderCtrl.translations['antibody.pdp.commerceCard.promotion.promocode']}}: {{promo.promoCode}} {{promo.promoTitle}} {{promo.promoDescription}}. {{$productOrderCtrl.translations['antibody.pdp.commerceCard.promotion.learnmore']}}

Please note: We are reviewing Western blot images included in the antibody testing data in our catalog, including those provided by third parties. Unless expressly labeled or annotated as “raw-unedited”, Western blot images included in the antibody testing data in our catalog may have been edited, optimized or otherwise adjusted for presentation.
产品信息
14600-1-AP
种属反应
已发表种属
宿主/亚型
分类
类型
抗原
偶联物
形式
浓度
规格
纯化类型
保存液
内含物
保存条件
运输条件
产品详细信息
This antibody can cross react with MAP1LC3A, MAP1LC3B, and MAP1LC3C.
Immunogen sequence: MPSEKTFKQ RRTFEQRVED VRLIREQHPT KIPVIIERYK GEKQLPVLDK TKFLVPDHVN MGELIKIIRR RLQLNANQAF FLLVNGHSMV SVSTPISEVY ESEKDEDGFL YMVYASQETF GMKLSV (1-125 aa encoded by B C067797)
靶标信息
Autophagy is a process of intracellular bulk degradation in which cytoplasmic components, including organelles, are sequestered within double-membrane vesicles that deliver the contents to the lysosome/vacuole for degradation. During macroautophagy, the sequestering vesicles, termed autophagosomes, fuse with the lysosome or vacuole resulting in the delivery of an inner vesicle (autophagic body) into the lumen of the degradative compartment. There are 16 proteins participating in the autophagy pathway in human. The autophagy protein LC3, a mammalian homologue of Atg8, was originally identified as microtubule-associated protein 1 light chain 3. It is a component of both the MAP1A and MAP1B microtubule-binding domains and the heavy-chain independent regulation of LC3 expression might modify MAP1 microtubule-binding activity during development. LC3 is the only known mammalian protein identified that stably associates with the autophagosome membranes. LC3-I is cytosolic and LC3-II is membrane bound and enriched in the autophagic vacuole fraction. The detection of LC3-I to LC3-II conversion is a useful and sensitive marker for distinguishing autophagy in mammalian cells.
仅用于科研。不用于诊断过程。未经明确授权不得转售。
生物信息学
蛋白别名: Autophagy-related protein LC3 A; Autophagy-related protein LC3 B; Autophagy-related ubiquitin-like modifier LC3 A; Autophagy-related ubiquitin-like modifier LC3 B; MAP1 light chain 3-like protein 1; MAP1 light chain 3-like protein 2; MAP1A/1B light chain 3 A; MAP1A/1B light chain 3 B; MAP1A/MAP1B LC3 A; MAP1A/MAP1B LC3 B; MAP1A/MAP1B light chain 3 A; MAP1A/MAP1B light chain 3 B; Microtubule-associated protein 1 light chain 3 alpha; Microtubule-associated protein 1 light chain 3 beta; microtubule-associated proteins 1A/1B light chain 3; Microtubule-associated proteins 1A/1B light chain 3A; Microtubule-associated proteins 1A/1B light chain 3B
基因别名: 1010001C15Rik; 1010001H21Rik; 4922501H04Rik; Atg8; LC3; LC3a; LC3b; Map1alc3; Map1lc3; Map1lc3a; Map1lc3b; Mpl3; zbs559
UniProt ID: (Rat) Q6XVN8, (Mouse) Q91VR7, (Rat) Q62625, (Mouse) Q9CQV6
Entrez Gene ID: (Rat) 362245, (Mouse) 66734, (Rat) 64862, (Mouse) 67443




